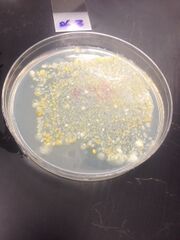

Uploads by Valerie Moon
From OpenWetWare
Jump to navigationJump to search
This special page shows all uploaded files.
| Date | Name | Thumbnail | Size | Description |
|---|---|---|---|---|
| 00:06, 22 March 2014 | Day 16.tiff (file) |  |
160 KB | |
| 00:04, 22 March 2014 | Day 11.tiff (file) |  |
135 KB | |
| 00:02, 22 March 2014 | Day 8 b.tiff (file) |  |
134 KB | |
| 23:59, 21 March 2014 | Day 8 a.tiff (file) |  |
135 KB | |
| 23:56, 21 March 2014 | Day 8 .tiff (file) |  |
149 KB | |
| 23:54, 21 March 2014 | Day 6 .tiff (file) |  |
128 KB | |
| 23:51, 21 March 2014 | Day 3.tiff (file) |  |
180 KB | |
| 23:48, 21 March 2014 | Day 1 .tiff (file) |  |
90 KB | |
| 04:13, 28 February 2014 | PCR results table.tiff (file) |  |
246 KB | |
| 20:00, 27 February 2014 | Food web .jpg (file) |  |
81 KB | |
| 19:49, 27 February 2014 | Arthropods activity .tiff (file) |  |
63 KB | |
| 19:47, 27 February 2014 | Arthropods .jpg (file) |  |
37 KB | |
| 18:41, 27 February 2014 | Invertebrates table.tiff (file) |  |
88 KB | |
| 16:52, 27 February 2014 | Transect map .jpg (file) |  |
44 KB | |
| 16:41, 27 February 2014 | Black bread mold .jpg (file) |  |
25 KB | |
| 16:37, 27 February 2014 | 5 plant specimens .tiff (file) |  |
129 KB | |
| 16:28, 27 February 2014 | 5 plant samples .jpg (file) |  |
24 KB | |
| 18:17, 22 February 2014 | Bacterial colony table copy.jpg (file) |  |
95 KB | |
| 03:41, 17 February 2014 | Colonies 2.jpg (file) |  |
111 KB | |
| 03:34, 17 February 2014 | Tet table .jpg (file) |  |
98 KB | |
| 03:15, 17 February 2014 | Tet 3.jpg (file) | |
33 KB | |
| 03:13, 17 February 2014 | Tet 2.jpg (file) |  |
33 KB | |
| 03:11, 17 February 2014 | Tet 1.jpg (file) |  |
24 KB | |
| 02:52, 17 February 2014 | Table 1 copy.jpg (file) |  |
61 KB | |
| 02:29, 17 February 2014 | Hay culture infusion lab 3.jpg (file) |  |
26 KB | |
| 21:26, 9 February 2014 | Dilutionss.jpg (file) |  |
30 KB | |
| 21:09, 9 February 2014 | Transect2a.jpg (file) |  |
33 KB | |
| 21:06, 9 February 2014 | Transect1a.jpg (file) |  |
37 KB | |
| 20:37, 9 February 2014 | Photo-2 copy.jpg (file) |  |
29 KB |